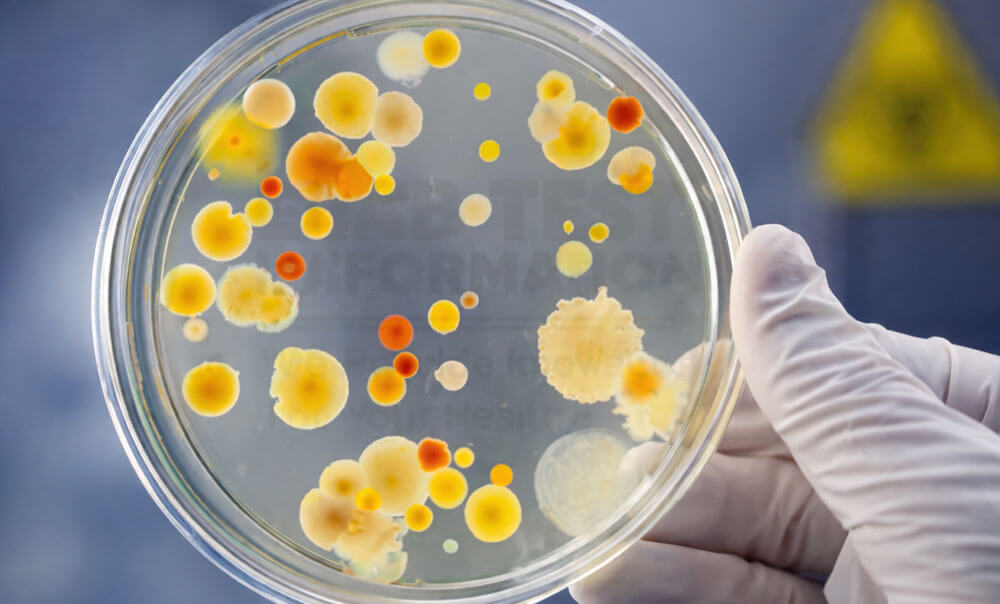
Culture and Sensitivity Testing

Culture and Sensitivity testing is a specialized laboratory investigation used to identify infectious microorganisms and determine the most effective antibiotics for treatment. At Precision Superspeciality Clinic and Diagnostics, we provide accurate culture and sensitivity testing to support targeted and effective infection management.
This test involves growing bacteria or fungi from clinical samples and testing their response to various antibiotics. It helps clinicians choose the most appropriate treatment while reducing the risk of antibiotic resistance.
Types of Samples Tested
- Blood
- Urine
- Sputum
- Stool
- Wound swabs and body fluids
Why Culture & Sensitivity Testing Is Important
Culture and sensitivity testing helps accurately diagnose bacterial and fungal infections, guides appropriate antibiotic therapy, and monitors treatment effectiveness. It plays a crucial role in preventing misuse of antibiotics and improving patient outcomes.
Why Choose Our Diagnostic Centre
Our diagnostic centre follows strict microbiological protocols, uses advanced laboratory techniques, and maintains high-quality standards to ensure reliable results. We focus on accuracy, timely reporting, and patient safety throughout the testing process.
Precision Superspeciality Clinic & Diagnostics is committed to delivering precise culture and sensitivity testing services to support effective infection diagnosis and treatment planning.